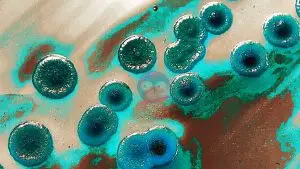
Turquoisity
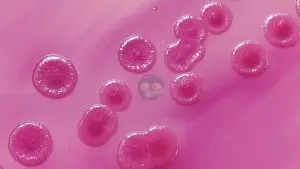
Original

Einzelwerke
Sunflowers
Ein Pilz, der aussieht, wie wunderschöne Sonnenblumen.
- Titel des Bildes: Sunflowers
 - Beschreibung: Makroaufnahme von Trychophyton violaceum
 - Material: Alu-Dibond butlerfinished mit Metall Effekt 3 mm, glänzendem UV Schutzlaminat veredelt
 - Format: 35x20 cm
 - limitierte Auflage 25
 - signiert und mit Zertifikat
 
Preis: 249 €
Pink Soul
Auf diesem Bild sieht man eine einzelne Kolonie von Enterobacter cloacae auf einem Chromagar. Ursprünglich wachsen die Kolonien türkisfarben, aber in einem schönen Pink sind sie noch hübscher. Besonders faszinierend ist die Spiegelung in so einer kleiner Bakterienkolonie.
- Titel des Bildes: Pink Soul
 - Beschreibung: Enterobacter cloacae
 - Druck: Kunstposter
 - Format: 30x30 cm
 
Preis: 49 €
Brilliance
So schön kann Genitalflora sein, kultiviert auf Blutagar. Besonders hervorzuheben ist hier die beeindruckende Bakterienspezies Vagococcus fluvialis.
- Titel des Bildes: Brilliance
 - Beschreibung: Genitalflora
 - Druck: Kunstposter
 - Format: 30x20 cm
 
Preis: 49 €
Reddish Glasspiel
Hier sieht man das funkelnde Bakterium Pseudomonas fluorescens auf Bluagar. Er bildet in diesem Fall besonders schöne glasige Kolonien aus. Das Bild zeigt in beeindruckender Art und Weise, dass Mikroorganismen auch digital unbearbeitet wunderschön sind. 
- Titel des Bildes: Reddish Glasspiel
 - Beschreibung: Pseudomonas fluorescens
 - Druck: Kunstposter
 - Format: 30x20 cm
 
Preis: 49 €
Turquoisity
Hier sieht man wunderschöne Kolonien von Escherichia coli auf MacConkey Agar. Das Bild wurde digital bearbeitet und so erscheinen die Kolonien in einem tollen Türkis.
- Titel des Bildes: Turquoisity
 - Beschreibung: Escherichia coli
 - Druck: Kunstposter
 - Format: 30x20 cm
 
Preis: 49 €
Black Beauty
Bei diesem wunderschönen Bild handelt es sich um die Bakterien Escherichia coli und Klebsiella spp. auf CPSE Agar. Das Bild wurde digital bearbeitet und erscheint so in einem beautiful black mit rot orangem Hintergrund.
- Titel des Bildes: Black Beauty
 - Beschreibung: Escherichia coli und Klebsiella spp.
 - Druck: Kunstposter
 - Format: 30x30 cm
 
Preis: 49 €
Haben Sie Interesse an einem dieser tollen Kunstwerke, dann kontaktieren Sie mich.